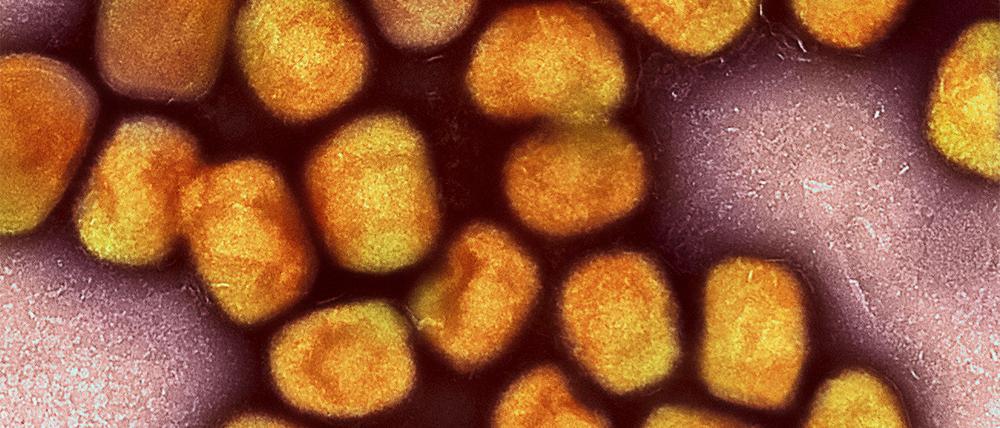

© dpa/NIAID
Zahlen zuletzt deutlich angestiegen: Mehr Mpox-Fälle in Berlin als in Vorjahren
Nach einem Rückgang während der Sommermonate werden in der Hauptstadt wieder mehr Mpox-Fälle gemeldet. In diesem Jahr sind es bereits mehr Infektionen als in den beiden Vorjahren zusammen.
Stand:
In diesem Jahr sind in Berlin bereits 160 Infektionen mit dem Mpox-Virus bekanntgeworden. Das sind mehr als in den beiden Vorjahren zusammen, wie aus dem aktuellen Wochenbericht des Landesamtes für Gesundheit und Soziales (Lageso) hervorgeht. Demnach gab es 2024 insgesamt 68 Fälle und im Jahr 2023 waren es 87 Infektionen.
Seit Juli gab es den Angaben nach einen Rückgang der wöchentlich gemeldeten Fälle, mit null bis vier Infektionen pro Woche. Zuletzt wurden dem Lageso jedoch neun Mpox-Fällen übermittelt – deutlich mehr als in den Wochen zuvor. Betroffen seien ausschließlich Männer zwischen im Alter zwischen 20 und 60 Jahren. Von den bereits ermittelten Männern waren fünf gegen Mpox geimpft.
Zwei Dosen für Grundimmunisierung erforderlich
Mpox, früher auch unter Affenpocken bekannt, ist eine Viruserkrankung. Sie wird durch engen Körperkontakt übertragen, etwa beim Sex. Das Virus löst vor allem Hautausschlag aus, aber auch Fieber und Muskelschmerzen.
Bestimmten Personengruppen in Deutschland wird eine Impfung gegen Mpox empfohlen. Dazu zählen unter anderem Männer, die Sex mit Männern haben und häufig den Partner wechseln. Für eine Grundimmunisierung sind zwei Dosen erforderlich. (dpa)
- showPaywall:
- false
- isSubscriber:
- false
- isPaid: